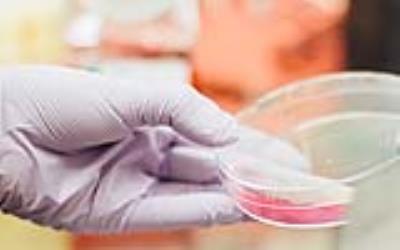

09 August 2018 | Binder GmbH
BINDER brings all information together
What you need to know about CO2 incubators… BINDER incubators have so much to offer. All tips and tricks surrounding them can now be found on the pillar page.
All information on CO2 incubators at a glanceThe gassed incubator from BINDER, otherwise known as the CO2 incubator, is very popular with users. In order to ensure that these users have all the information they need at a glance, BINDER has brought everything together on a pillar page. This is an enhancement to the already very detailed BINDER website and provides readers with lots of new options. It starts with an explanation of what an incubator actually is. It sounds pretty simple: inside a CO2 incubator, an atmosphere is created that is as natural as possible in order to develop cell and tissue cultures. However, conditions such as the humidity, temperature, and CO2 content must be exactly right. And what can achieve these optimum conditions better than a BINDER chamber?
Anyone who wants to know more just has to see the "Structure and function of a CO2 incubator" section, which includes a video showing the special features of the BINDER incubator, amongst other things. It is made clear here once again that BINDER relies on the very best materials and state-of-the-art technology. The question of how a CO2 chamber is used is particularly exciting. This section gives the reader an insight into incubator applications and reports on satisfied customers who can look back on many years of experience with BINDER CO2 chambers, which are used, for example, in the field of artificial fertilization. The fact that BINDER is a key player when it comes to cancer research is also made abundantly clear.
So, which CO2 incubator is the right one? The new page will give users the answers to this question too. Click here and take a look − it will definitely be worth it.